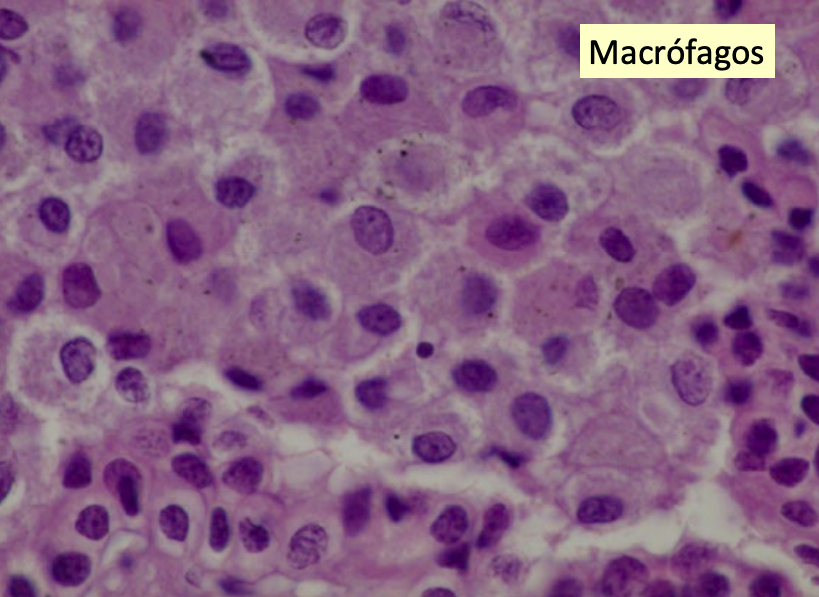

Tema 17 - Inflamación - 27/10
Clase del 27/10 Presentación
TEMA 17: INFLAMACIÓN
Hay 5 signos de inflamación: Calor, Rubor, tumefacción, dolor y PERDIDA DE FUNCIÓN
- Antemortem
- Postmortem (No ha sangrado)
Conceptos generales
Definición
Reacción orgánica compleja frente a agresiones, originada por una gran diversidad de agentes.
La reacción inflamatoria consiste en:
- Cambios en la red vascular terminal, sangre y tejido conjuntivo.
- Migración y activación leucocitaria.
- Activación de reacciones sistémicas.
Hecho distintivo:
Reacción de los vasos sanguíneos (respuesta vascular), acumulación de fluidos y células (respuesta celular) en la matriz extracelular frente a una agresión.
Objetivos:
- Acabar con la causa.
- Reparar el daño.
Inflamación y Reparación
- Coexisten como manifestaciones de un mismo proceso.
- Objetivo: Curación y reconstrucción.
- La reparación no finaliza hasta que se ha neutralizado la causa.
- Puede realizarse por regeneración, por cicatrización o por una combinación de ambos procesos.
Características del proceso inflamatorio:
- Siempre se inicia tras una agresión tisular.
- Solo ocurre en vida.
- Presenta variaciones según el agente patógeno, especie y edad.
Signos cardinales de la inflamación
(Según Celso y Galeno, completado por Virchow):
- Calor
- Rubor
- Tumefacción
- Dolor
- Disfunción
Causas de la inflamación
Físicas
- Traumatismos.
- Radiaciones.
- Calor.
- Frío.
Químicas
- Agentes orgánicos (ej. paraquat).
- Agentes inorgánicos (ácidos o bases).
Biológicas
- Bacterias.
- Virus.
- Hongos.
- Parásitos.
Inmunológicas
- Hipersensibilidad (complejos Ag-Ac, respuestas mediadas por células).
Otras causas
- Necrosis de cualquier origen.
- Cuerpos extraños.
Terminología
Regla general
- Sufijo: “-itis”.
- Prefijo: tejido u órgano afectado.
Ejemplos:
Hepatitis, nefritis, miocarditis, osteítis, tendinitis, pielitis, cistitis, proctitis, tiflitis, queratitis.
- Arterias → arteritis (endo-, peri-, panarteritis).
- Serosas → peritonitis, pleuritis.
- Cápsulas de órganos → prefijo “peri-” (p. ej. perihepatitis).
Excepciones
- Neumonía (no “pulmonitis”).
- Angina: inflamación del tejido linfoide de la glotis (humana).
- Coriza: inflamación de la mucosa nasal (aves).
Posibles confusiones:
- Linfangitis → vasos linfáticos.
- Linfadenitis → nódulos linfáticos.
Terminología anatómica de la inflamación
| Órgano / Tejido | Inflamación |
|---|---|
| Abomaso | Abomasitis |
| Glándula | Adenitis |
| Adrenal | Adrenalitis |
| Saco aéreo | Aerosaculitis |
| Albugínea (testículo) | Albuginitis |
| Alvéolo dentario | Alveolitis |
| Amígdala / tonsila | Amigdalitis |
| Arteria | Arteritis |
| Articulación | Artritis |
| Glande | Balanitis |
| Párpado | Blefaritis |
| Párpado y conjuntiva | Blefaroconjuntivitis |
| Bronquiolo | Bronquiolitis |
| Bronquio | Bronquitis |
| Bolsa sinovial | Bursitis |
| Corazón | Carditis |
| Tejido conjuntivo | Celulitis |
| Cérvix | Cervicitis |
| Cérvix y vagina | Cervicovaginitis |
| Vejiga | Cistitis |
| Hígado y conductos biliares | Colangiohepatitis |
| Conductos biliares | Colangitis |
| Vesícula biliar | Colecistitis |
| Colon | Colitis |
| Cartílago | Condritis |
| Conjuntiva ocular | Conjuntivitis |
| Glándula lagrimal | Dacrioadenitis |
| Piel (dermis) | Dermatitis |
| Ligamento | Desmitis |
| Disco intervertebral | Discospondilitis |
| Duodeno | Duodenitis |
| Encéfalo | Encefalitis |
| Encéfalo y médula espinal | Encefalomielitis |
| Endocardio | Endocarditis |
| Estómago | Gastritis |
| Estómago e intestino | Gastroenteritis |
| Encía | Gingivitis |
| Glomérulo renal | Glomerulonefritis |
| Lengua | Glositis |
| Hígado | Hepatitis |
| Íleon | Ileítis |
| Iris | Iriditis |
| Iris y cuerpo ciliar | Iridociclitis |
| Laringe | Laringitis |
| Laringe y tráquea | Laringotraqueitis |
| Sustancia blanca del encéfalo | Leucoencefalitis |
| Nódulos linfáticos | Linfadenitis |
| Vasos linfáticos | Linfangitis |
| Glándula mamaria | Mamitis / Mastitis |
| Meninges | Meningitis |
| Meninges y encéfalo | Meningoencefalitis |
| Meninges, encéfalo y médula espinal | Meningoencefalomielitis |
| Útero | Metritis |
| Médula espinal | Mielitis |
| Músculo esquelético | Miositis |
| Miocardio | Miocarditis |
| Riñón | Nefritis |
| Pulmón | Neumonía |
| Nervio | Neuritis |
| Diente | Odontitis |
| Ojo | Oftalmitis |
| Omaso | Omasitis |
| Ombligo | Onfalitis |
| Ovario | Ooforitis |
| Testículo | Orquitis |
| Panículo adiposo | Paniculitis |
| Páncreas | Pancreatitis |
| Riñón (pelvis) | Pielonefritis |
| Pericardio | Pericarditis |
| Periostio | Periostitis |
| Peritoneo | Peritonitis |
| Pleura | Pleuritis |
| Pleura y pulmón | Pleuroneumonía |
| Colon | Proctitis |
| Próstata | Prostatitis |
| Ciego | Tiflitis |
| Ciego y colon | Tiflocolitis |
| Tiroides | Tiroiditis |
| Tráquea | Traqueitis |
| Uretra | Uretritis |
| Vagina | Vaginitis |
| Vasos | Vasculitis |
| Vulva | Vulvitis |
| Vulva y vagina | Vulvovaginitis |
Términos utilizados en inflamación
IMPORTANTE Exudado es inflamatorio, turbio y el Transudado NO es inflamatorio, es transparente.
- Edema: exceso de líquido en espacio extravascular. Puede ser inflamatorio o no
- Exudación: salida de componentes sanguíneos al exterior.
- Exudado: líquido extravascular inflamatorio con proteínas y restos celulares (p > 1,020).
- Trasudado: ultrafiltrado del plasma sin alteración de permeabilidad vascular (p < 1,012).
Diferencias entre trasudado y exudado
| Característica | Trasudado | Exudado |
|---|---|---|
| Proteínas | <3% | >5% |
| Coagula | No | Sí |
| Células | No | Sí |
| Densidad | 1.012 | 1.020 |
| Etiología | No inflamatoria | Inflamatoria |
Tipos de exudado
- Seroso.
- Fibrinoso.
- Mucoso / catarral.
- Purulento.
- Hemorrágico.
Clasificación de las inflamaciones
Por gravedad
- Leve: poca destrucción, poco exudado.
- Moderada: congestión y acúmulo leucocitario.
- Grave: gran destrucción y extensión.
Por distribución
- Focal: un solo foco.
- Multifocal: varios focos separados por tejido normal.
- Coalescente: unión de varios focos.
- Localmente extensa (zonal): afecta gran parte del órgano.
- Difusa: todo el tejido afectado.
*EN PULMON dorsal caudal suele haber parasitos, craneal ventral bacterias, si es en todo (difusa), virica.
Por duración
| Tipo | Características |
|---|---|
| Sobreaguda | Inicio rápido (minutos), estímulo potente, fenómenos vasculares intensos, evolución breve (horas). |
| Aguda | Inicio lento (horas a 3-4 días), cambios vasculares y migración leucocitaria, signos cardinales. |
| Subaguda | Dura de pocos a varios días, disminuyen fenómenos vasculares, migran monocitos. |
| Crónica | Prolongada, sin fenómenos vasculares, linfocitos y macrófagos predominan, reparación. |
| Crónica activa | Exacerbación aguda de una lesión crónica. |
En Inflamaciones agudas vemos neutrofilos (Nucleo lobulado), en subagudas vemos neutrofilos y MONOCITOS y en cronicas vemos mayoritariamente Macrofagos
Nomenclatura de las inflamaciones Importante
- Órgano afectado.
- Fenómeno característico (tipo de exudado, necrosis...).
- Tiempo de evolución.
- Extensión (si afecta total o parcialmente).
- Gravedad.
¿A qué órgano afecta?¿Qué tipo de exudado la caracteriza? ¿Cuánto hace que ha comenzado? 2 días Enteritis fibrionsa?
(Fin del documento transcrito de “Tema 17 – Inflamación.pdf”)

No comments to display
No comments to display